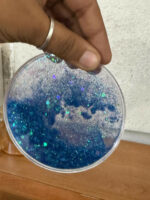
Blue Glitter Resin Tea Coaster Round Sparkle Cup Coaster for Table Decor (MUG NOT INCLUDED) - Image 5

Blue Glitter Resin Tea Coaster Round Sparkle Cup Coaster for Table Decor (MUG NOT INCLUDED)
₹52.00
Add elegance to your drinkware setup with this Blue Glitter Resin Tea Coaster.
Designed with a stunning glitter pattern, this coaster not only protects your table from heat, spills and scratches but also elevates your décor with a modern, stylish look.
Made from high-quality resin, it is lightweight, durable and easy to maintain. Perfect for daily use at home, office, cafés or gifting purposes, this coaster blends functionality with aesthetic appeal.
🔹 KEY FEATURES
• Premium Blue Glitter Finish – Eye-catching sparkle design enhances table & desk décor
• Heat & Stain Resistant – Protects surfaces from hot tea, coffee and drink stains
• Durable Resin Material – Strong, long-lasting and easy to clean
• Perfect Round Size – Suitable for tea cups, coffee mugs, glasses and small bowls
• Great Gifting Option – Ideal for housewarming, birthdays, festivals & return gifts
blue glitter tea coaster, resin cup coaster, coffee mug coaster, round table coaster, decorative tea coaster, drink coaster for table, heat resistant coaster, resin coaster for cups, sparkle coaster, kitchen table accessories
| Weight | 0.067 lbs |
|---|


MAECENAS IACULIS
Vestibulum curae torquent diam diam commodo parturient penatibus nunc dui adipiscing convallis bulum parturient suspendisse parturient a.Parturient in parturient scelerisque nibh lectus quam a natoque adipiscing a vestibulum hendrerit et pharetra fames nunc natoque dui.
ADIPISCING CONVALLIS BULUM
- Vestibulum penatibus nunc dui adipiscing convallis bulum parturient suspendisse.
- Abitur parturient praesent lectus quam a natoque adipiscing a vestibulum hendre.
- Diam parturient dictumst parturient scelerisque nibh lectus.
Scelerisque adipiscing bibendum sem vestibulum et in a a a purus lectus faucibus lobortis tincidunt purus lectus nisl class eros.Condimentum a et ullamcorper dictumst mus et tristique elementum nam inceptos hac parturient scelerisque vestibulum amet elit ut volutpat.

Reviews
There are no reviews yet.